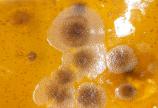

BC kelp forests face new threat
- Anne MacLaurin

A very small creature is threatening the health of BC’s giant kelp forests: bryozoans. They’re tiny white coral-like crustaceans that attach themselves to kelp, reducing reproduction and overall health of kelp beds.
Researchers suspect that changing ocean temperatures are causing active growth of the tiny animal that thrives in warmer, less dynamic water. First Nations along BC’s central coast have spotted the kelp-encrusting bryozoan (KEB) in a growing number of kelp beds—and the presence of KEB may impact the development of juvenile Pacific salmon that rely on healthy kelp beds for protection.
“We saw an increase in kelp-encrusted bryozoans last year in the Broughton Archipelago. Through our BC Kelp Resilience Project, we monitor kelp health and the increase of bryozoans are the latest threat to our kelp forests.”
—Maycira Costa, UVic geography professor
“Although we are starting to understand kelp forest changes in BC, little is known about the impact and conditions that lead to KEB increases,” adds Costa.
Costa and her partners will be collecting data on ocean temperature, light, currents and the level of salinity in the water. They will also capture under- and above-water images, and use remote-sensing data to quantify kelp-encrusting bryozoan. The data will inform scientists on environmental conditions conducive to kelp health and the presence of bryozoans.

“We see less or no bryozoan on kelp living in dynamic, fast-flowing water,” says Costa. “We need to better understand the environmental conditions in each region.”
Costa also has a plan to invite citizen scientists into the study. She would like kayak clubs to be involved in the kelp monitoring project.
“Kayak club members can submit photos of kelp they see out in their travels,” says Costa. “Collecting secondary evidence will contribute to our understanding of kelp health.”